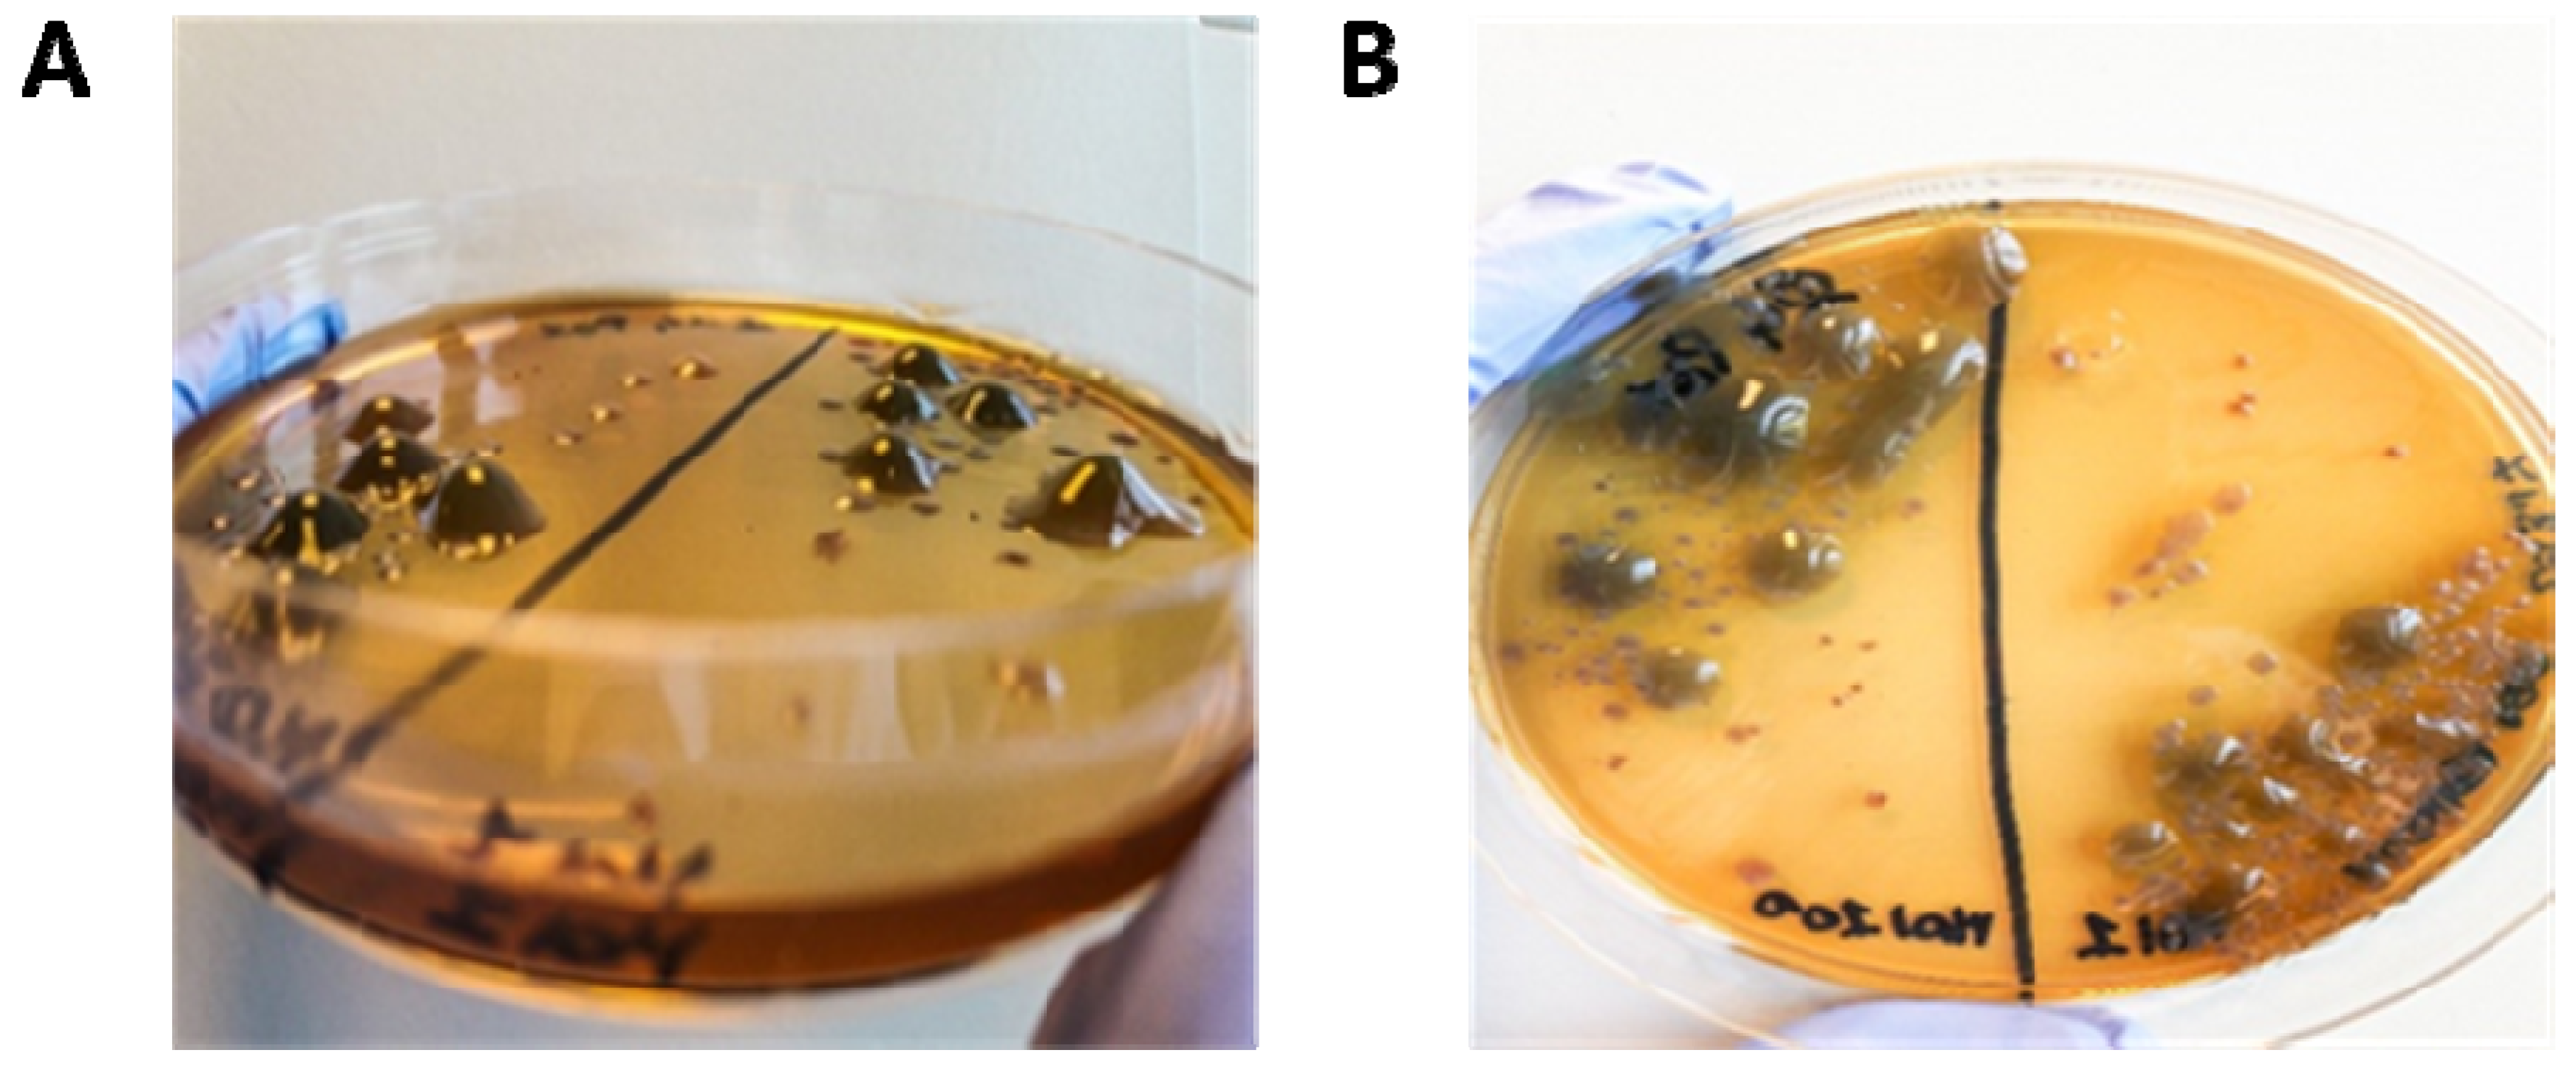
Microorganisms 09 00478 g006 Microorganisms 09 00478 g006

In Vitro Newly Isolated Environmental Phage Activity against Biofilms Preformed by Pseudomonas aeruginosa from Patients with Cystic Fibrosis
Abstract
1. Introduction
2. Materials and Methods
2.1. Laboratory PA, CF PA Isolates and Culture Conditions
2.2. Phage Isolation and Purification
2.3. Morphological Phage Characterization
2.4. Functional Phage Characterization
2.5. Cross-Activity Phage Evaluation
2.6. Phage Activity against PA Biofilms
2.7. Phage and Antibiotic Combined Treatment Effect on PA Biofilms
2.8. Supernatant PA Phenotypes and Antibiotic Sensitivity Tests
2.9. Phage-CF PA Planktonic Cell Infection Kinetics
2.10. Statistical Analysis
3. Results
3.1. Phage Isolation and Purification
3.2. Morphological Phage Characterization
3.3. Functional Phage Characterization
3.4. Cross Activity Phage Evaluation on Clinical CF PA
3.5. Phage Activity against Preformed PA Biofilms
3.6. Phage and Antibiotic Combined Treatment Effect on PA Biofilms
3.7. Supernatant CF PA Phenotypes and Antibiotic Sensitivity Tests
3.8. Phage-CF PA Planktonic Cell Infection Kinetics
4. Discussion
5. Conclusions
Supplementary Materials
Author Contributions
Funding
Institutional Review Board Statement
Informed Consent Statement
Data Availability Statement
Acknowledgments
Conflicts of Interest
References
- Gibson, R.L.; Burns, J.L.; Ramsey, B.W. Pathophysiology and management of pulmonary infections in cystic fibrosis. Am. J. Respir. Crit. Care Med. 2003, 168, 918–951. [Google Scholar] [CrossRef] [PubMed]
- Stuart, B.; Lin, J.H.; Mogayzel, P.J. Early eradication of Pseudomonas aeruginosa in patients with cystic fibrosis. Paediatr. Respir. Rev. 2010, 11, 177–184. [Google Scholar] [CrossRef] [PubMed]
- Frederiksen, B.; Koch, C.; Høiby, N. Antibiotic treatment of initial colonization with Pseudomonas aeruginosa postpones chronic infection and prevents deterioration of pulmonary function in cystic fibrosis. Pediatr. Pulmonol. 1997, 23, 330–335. [Google Scholar] [CrossRef]
- Moreau-Marquis, S.; Stanton, B.A.; O’Toole, G.A. Pseudomonas aeruginosa biofilm formation in the cystic fibrosis airway. Pulm. Pharmacol. Ther. 2008, 21, 595–599. [Google Scholar] [CrossRef]
- Rosenfeld, M.; Ramsey, B.W.; Gibson, R.L. Pseudomonas acquisition in young patients with cystic fibrosis: Pathophysiology, diagnosis, and management. Curr. Opin. Pulm. Med. 2003, 9, 492–497. [Google Scholar] [CrossRef] [PubMed]
- Thiel, K. Old dogma, new tricks‒21st Century phage therapy. Nat. Biotechnol. 2004, 22, 31–36. [Google Scholar] [CrossRef]
- Hurley, M.N.; Cámara, M.; Smyth, A.R. Novel approaches to the treatment of Pseudomonas aeruginosa infections in cystic fibrosis. Eur. Respir. J. 2012, 40, 1014–1023. [Google Scholar] [CrossRef]
- Chegini, Z.; Khoshbayan, A.; Taati Moghadam, M.; Farahani, I.; Jazireian, P.; Shariati, A. Bacteriophage therapy against Pseudomonas aeruginosa biofilms: A review. Ann. Clin. Microbiol. Antimicrob. 2020, 19, 1–17. [Google Scholar] [CrossRef]
- Azeredo, J.; Sutherland, I. The use of phages for the removal of infectious biofilms. Curr. Pharm. Biotechnol. 2008, 9, 261–266. [Google Scholar] [CrossRef]
- Rossitto, M.; Fiscarelli, E.V.; Rosati, P. Challenges and promises for planning future clinical research into bacteriophage therapy against Pseudomonas aeruginosa in cystic fibrosis. An argumentative review. Front. Microbiol. 2018, 9, 775. [Google Scholar] [CrossRef]
- Kropinski, A.M.; Mazzocco, A.; Waddell, T.E.; Lingohr, E.; Johnson, R.P. Enumeration of bacteriophages by double agar overlay plaque assay. Methods Mol. Biol. 2009, 501, 69–76. [Google Scholar] [CrossRef] [PubMed]
- Pires, D.; Sillankorva, S.; Faustino, A.; Azeredo, J. Use of newly isolated phages for control of Pseudomonas aeruginosa PAO1 and ATCC 10145 biofilms. Res. Microbiol. 2011, 162, 798–806. [Google Scholar] [CrossRef]
- Garbe, J.; Wesche, A.; Bunk, B.; Kazmierczak, M.; Selezska, K.; Rohde, C.; Sikorski, J.; Rohde, M.; Jahn, D.; Schobert, M. Characterization of JG024, a Pseudomonas aeruginosa PB1-like broad host range phage under simulated infection conditions. BMC Microbiol. 2010, 10, 1–10. [Google Scholar] [CrossRef]
- Kutter, E. Phage host range and efficiency of plating. Methods Mol. Biol. 2009, 501, 141–149. [Google Scholar] [CrossRef]
- Pompilio, A.; Crocetta, V.; De Nicola, S.; Verginelli, F.; Fiscarelli, E.; Di Bonaventura, G. Cooperative pathogenicity in cystic fibrosis: Stenotrophomonas maltophilia modulates Pseudomonas aeruginosa virulence in mixed biofilm. Front. Microbiol. 2015, 6, 951. [Google Scholar] [CrossRef] [PubMed]
- Chaudhry, W.N.; Concepcion-Acevedo, J.; Park, T.; Andleeb, S.; Bull, J.J.; Levin, B.R. Synergy and order effects of antibiotics and phages in killing Pseudomonas aeruginosa biofilms. PLoS ONE 2017, 12, e0168615. [Google Scholar] [CrossRef] [PubMed]
- Nouraldin, A.A.M.; Baddour, M.M.; Harfoush, R.A.H.; Essa, S.A.M. Bacteriophage-antibiotic synergism to control planktonic and biofilm producing clinical isolates of Pseudomonas aeruginosa. Alexandria J. Med. 2016, 52, 99–105. [Google Scholar] [CrossRef]
- Coulter, L.; McLean, R.; Rohde, R.; Aron, G. Effect of bacteriophage infection in combination with tobramycin on the emergence of resistance in Escherichia coli and Pseudomonas aeruginosa biofilms. Viruses 2014, 6, 3778–3786. [Google Scholar] [CrossRef]
- Torres-Barceló, C.; Arias-Sánchez, F.I.; Vasse, M.; Ramsayer, J.; Kaltz, O.; Hochberg, M.E. A window of opportunity to control the bacterial pathogen Pseudomonas aeruginosa combining antibiotics and phages. PLoS ONE 2014, 9. [Google Scholar] [CrossRef]
- Torres-Barceló, C.; Franzon, B.; Vasse, M.; Hochberg, M.E. Long-term effects of single and combined introductions of antibiotics and bacteriophages on populations of Pseudomonas aeruginosa. Evol. Appl. 2016, 9, 583–595. [Google Scholar] [CrossRef]
- Chaudhry, W.; Lee, E.; Worthy, A.; Weiss, Z.; Grabowicz, M.; Vega, N.; Levin, B. Mucoidy, a general mechanism for maintaining lytic phage in populations of bacteria. FEMS Microbiol. Ecol. 2020, 96, fiaa162. [Google Scholar] [CrossRef] [PubMed]
- Chan, B.K.; Stanley, G.; Modak, M.; Koff, J.L.; Turner, P.E. Bacteriophage therapy for infections in CF. Pediatr. Pulmonol. 2021, 56, S4–S9. [Google Scholar] [CrossRef] [PubMed]
- Pourcel, C.; Midoux, C.; Vergnaud, G.; Latino, L. The basis for natural multiresistance to phage in Pseudomonas aeruginosa. Antibiotics 2020, 9, 339. [Google Scholar] [CrossRef] [PubMed]
- Betts, A.; Vasse, M.; Kaltz, O.; Hochberg, M.E. Back to the future: Evolving bacteriophages to increase their effectiveness against the pathogen Pseudomonas aeruginosa PAO1. Evol. Appl. 2013, 6, 1054–1063. [Google Scholar] [CrossRef]
- Danis-Wlodarczyk, K.; Vandenheuvel, D.; Jang, H.B.; Briers, Y.; Olszak, T.; Arabski, M.; Wasik, S.; Drabik, M.; Higgins, G.; Tyrrell, J.; et al. A proposed integrated approach for the preclinical evaluation of phage therapy in Pseudomonas infections. Sci. Rep. 2016, 6, 1–13. [Google Scholar] [CrossRef] [PubMed]
- Alemayehu, D.; Casey, P.G.; Mcauliffe, O.; Guinane, C.M.; Martin, J.G.; Shanahan, F.; Coffey, A.; Ross, R.P.; Hill, C. Bacteriophages φMR299-2 and φNH-4 can eliminate Pseudomonas aeruginosa in the murine lung and on cystic fibrosis lung airway cells. MBio 2012, 3, e00029-12. [Google Scholar] [CrossRef]
- Hanlon, G.W.; Denyer, S.P.; Olliff, C.J.; Ibrahim, L.J. Reduction in exopolysaccharide viscosity as an aid to bacteriophage penetration through Pseudomonas aeruginosa biofilms. Appl. Environ. Microbiol. 2001, 67, 2746–2753. [Google Scholar] [CrossRef]
- Danis-Wlodarczyk, K.; Olszak, T.; Arabski, M.; Wasik, S.; Majkowska-Skrobek, G.; Augustyniak, D.; Gula, G.; Briers, Y.; Jang, H.B.; Vandenheuvel, D.; et al. Characterization of the newly isolated lytic bacteriophages KTN6 and KT28 and their efficacy against Pseudomonas aeruginosa biofilm. PLoS ONE 2015, 10, e0127603. [Google Scholar] [CrossRef]
- Essoh, C.; Blouin, Y.; Loukou, G.; Cablanmian, A.; Lathro, S.; Kutter, E.; Thien, H.V.; Vergnaud, G.; Pourcel, C. The susceptibility of Pseudomonas aeruginosa strains from cystic fibrosis patients to bacteriophages. PLoS ONE 2013, 8, e72457. [Google Scholar] [CrossRef]
- Friman, V.P.; Soanes-Brown, D.; Sierocinski, P.; Molin, S.; Johansen, H.K.; Merabishvili, M.; Pirnay, J.P.; De Vos, D.; Buckling, A. Pre-adapting parasitic phages to a pathogen leads to increased pathogen clearance and lowered resistance evolution with Pseudomonas aeruginosa cystic fibrosis bacterial isolates. J. Evol. Biol. 2016, 29, 188–198. [Google Scholar] [CrossRef]
- Smith, E.E.; Buckley, D.G.; Wu, Z.; Saenphimmachak, C.; Hoffman, L.R.; D’Argenio, D.A.; Miller, S.I.; Ramsey, B.W.; Speert, D.P.; Moskowitz, S.M.; et al. Genetic adaptation by Pseudomonas aeruginosa to the airways of cystic fibrosis patients. Proc. Natl. Acad. Sci. USA 2006, 103, 8487–8492. [Google Scholar] [CrossRef]
- Morello, E.; Saussereau, E.; Maura, D.; Huerre, M.; Touqui, L.; Debarbieux, L. Pulmonary bacteriophage therapy on Pseudomonas aeruginosa cystic fibrosis strains: First steps towards treatment and prevention. PLoS ONE 2011, 6, e16963. [Google Scholar] [CrossRef] [PubMed]
- Henry, M.; Lavigne, R.; Debarbieux, L. Predicting in vivo efficacy of therapeutic bacteriophages used to treat pulmonary infections. Antimicrob. Agents Chemother. 2013, 57, 5961–5968. [Google Scholar] [CrossRef] [PubMed]
- Saussereau, E.; Vachier, I.; Chiron, R.; Godbert, B.; Sermet, I.; Dufour, N.; Pirnay, J.P.; De Vos, D.; Carrié, F.; Molinari, N.; et al. Effectiveness of bacteriophages in the sputum of cystic fibrosis patients. Clin. Microbiol. Infect. 2014, 20, O983–O990. [Google Scholar] [CrossRef]
- Davis, C.M.; McCutcheon, J.G.; Dennis, J.J. Aztreonam lysine increases the activity of phages E79 and phiKZ against Pseudomonas aeruginosa PA01. Microorganisms 2021, 9, 152. [Google Scholar] [CrossRef] [PubMed]

| Phage Names | Phage Morphologic and Growth Characteristics | ||||
|---|---|---|---|---|---|
| Head Length (nm) a | Tail Length (nm) a | Burst Size b (PFU/Cell Mean ± SD) | Latent Period (min) | Infection Cycle (min) | |
| Φ4_ZP1 | 75 | 22 | 8.5 ± 3.0 | 10 | 20 |
| Φ9_ZP2 | 64 | 20 | 11.0 ± 3.0 | 30 | 45 |
| Φ14_OBG | 72 | 35 | 12.7 ± 3.7 | 35 | 45 |
| Φ17_OBG | 64 | 20 | 34.0 ± 18.0 | 20 | 50 |
| Φ19_OBG | 89 | 21.5 | 4.0 ± 0.5 | 40 | 45 |
| Significant PA Biofilm Reduction Numbers (%) | ||||
|---|---|---|---|---|
| 4 h | 24 h | |||
| Phages Tested | MOI 1 | MOI 100 | MOI 1 | MOI 100 a |
| Φ4_ZP1 | 7/18 (38.8) | 9/18 (50.0) | 10/21 (47.6) | 7/21 (33.3) a |
| Φ9_ZP2 | 4/15 (26.6) b | 10/15 (66.6) b | 6/17 (35.2) | 8/17 (47.0) |
| Φ14_OBG | 6/18 (33.3) | 10/19 (52.6) | 10/22 (45.4) | 15/22 (68.1) a,c |
| Φ17_OBG | 14/25 (56.0) | 12/26 (46.1) | 10/31 (32.2) | 10/31 (32.2) c |
| Φ19_OBG | 11/24 (45.8) | 14/24 (58.3) | 6/24 (25.0) | 10/24 (41.6) |
| Total | 42/100 (42.0) | 55/102 (53.9) | 42/115 (36.5) | 50/115 (43.4) |
| Pa Isolates from Patients with CF and the Five Phages (Φ) Inducing MUC Pa Phenotype Switching | ||||||||||||||||
|---|---|---|---|---|---|---|---|---|---|---|---|---|---|---|---|---|
| Pa_Ph1 | Pa_Ph3 | Pa_Ph13 | Pa_Ph14 | Pa_Ph15 | Pa_Ph18 | Pa_Ph23 | Pa_Ph33 | |||||||||
| Antibiotics | WT | MUC (Φ19) | WT | MUC (Φ9) | WT | MUC (Φ17) | WT | MUC (Φ4) | WT | MUC (Φ19) | WT | MUC (Φ19) | WT | MUC (Φ14) | WT | MUC (Φ19) |
| AMK | 19 | 25 | 24 | 25 | 24 | 21 | 21 | 21 | 22 | 19 | 17 | 20 | 19 | 22 | 24 | 20 |
| ATM | 32 | 25 | 22 | 23 | 26 | 20 | 23 | 0 | 20 | 24 | 16 | 24 | 19 | 22 | 26 | 22 |
| FEP | 17 | 26 | 25 | 30 | 26 | 20 | 26 | 0 | 22 | 19 | 11 | 21 | 17 | 19 | 15 | 18 |
| CAZ | 26 | 28 | 24 | 28 | 28 | 20 | 24 | 0 | 24 | 20 | 18 | 24 | 18 | 20 | 28 | 16 |
| CIP | 24 | 28 | 35 | 28 | 30 | 15 | 28 | 28 | 0 | 29 | 13 | 26 | 24 | 16 | 30 | 25 |
| IPM | 32 | 24 | 23 | 27 | 21 | 14 | 23 | 7 | 25 | 26 | 0 | 26 | 0 | 12 | 21 | 25 |
| LVX | 18 | 23 | 24 | 24 | 24 | 13 | 24 | 19 | 0 | 18 | 0 | 20 | 20 | 10 | 24 | 19 |
| MPM | 40 | 24 | 29 | 22 | 34 | 12 | 28 | 0 | 25 | 28 | 16 | 35 | 0 | 12 | 28 | 30 |
| TZP | 35 | 27 | 24 | 28 | 28 | 18 | 25 | 0 | 28 | 16 | 24 | 16 | 19 | 16 | 26 | 20 |
| TOB | 17 | 30 | 23 | 27 | 23 | 24 | 21 | 23 | 0 | 21 | 21 | 23 | 21 | 26 | 24 | 23 |
Publisher’s Note: MDPI stays neutral with regard to jurisdictional claims in published maps and institutional affiliations. |
© 2021 by the authors. Licensee MDPI, Basel, Switzerland. This article is an open access article distributed under the terms and conditions of the Creative Commons Attribution (CC BY) license (http://creativecommons.org/licenses/by/4.0/).
Share and Cite
Fiscarelli, E.V.; Rossitto, M.; Rosati, P.; Essa, N.; Crocetta, V.; Di Giulio, A.; Lupetti, V.; Di Bonaventura, G.; Pompilio, A. In Vitro Newly Isolated Environmental Phage Activity against Biofilms Preformed by Pseudomonas aeruginosa from Patients with Cystic Fibrosis. Microorganisms 2021, 9, 478. https://doi.org/10.3390/microorganisms9030478
Fiscarelli EV, Rossitto M, Rosati P, Essa N, Crocetta V, Di Giulio A, Lupetti V, Di Bonaventura G, Pompilio A. In Vitro Newly Isolated Environmental Phage Activity against Biofilms Preformed by Pseudomonas aeruginosa from Patients with Cystic Fibrosis. Microorganisms. 2021; 9(3):478. https://doi.org/10.3390/microorganisms9030478
Chicago/Turabian StyleFiscarelli, Ersilia Vita, Martina Rossitto, Paola Rosati, Nour Essa, Valentina Crocetta, Andrea Di Giulio, Veronica Lupetti, Giovanni Di Bonaventura, and Arianna Pompilio. 2021. "In Vitro Newly Isolated Environmental Phage Activity against Biofilms Preformed by Pseudomonas aeruginosa from Patients with Cystic Fibrosis" Microorganisms 9, no. 3: 478. https://doi.org/10.3390/microorganisms9030478
APA StyleFiscarelli, E. V., Rossitto, M., Rosati, P., Essa, N., Crocetta, V., Di Giulio, A., Lupetti, V., Di Bonaventura, G., & Pompilio, A. (2021). In Vitro Newly Isolated Environmental Phage Activity against Biofilms Preformed by Pseudomonas aeruginosa from Patients with Cystic Fibrosis. Microorganisms, 9(3), 478. https://doi.org/10.3390/microorganisms9030478

